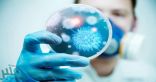
عقار جديد يحمي من النوبات القلبية ويحد من وفيات السرطان

أرشيف الوسم : السرطان
العنب يساعد على الوقاية من السرطان
وصلة دائمة لهذا المحتوى : https://www.mnbr.news/74759.html
تعرف على… الأطعمة الأفضل لحمايتك من السرطان
وصلة دائمة لهذا المحتوى : https://www.mnbr.news/74587.html
الحياة الصحية تساعد الآلاف على تجنب السرطان
وصلة دائمة لهذا المحتوى : https://www.mnbr.news/70969.html
تعرف على.. التقنية الجديدة لعلاج السرطان
وصلة دائمة لهذا المحتوى : https://www.mnbr.news/69911.html
الرياضة تحميك من السرطان
وصلة دائمة لهذا المحتوى : https://www.mnbr.news/69565.html
علاج السرطان بحقنة.. حلم توصل إليه باحثون أمريكيون (فيديو)
وصلة دائمة لهذا المحتوى : https://www.mnbr.news/64339.html
حقائق وأرقام “مفزعة” عن اليوم العالمي لمكافحة السرطان.. تعرف عليها
وصلة دائمة لهذا المحتوى : https://www.mnbr.news/64045.html
بضغطة “ريموت كنترول” علاج أخطر أنواع #السرطان في العالم!
وصلة دائمة لهذا المحتوى : https://www.mnbr.news/61608.html
اكتشاف 41 جينًا يتعرَّف على السرطان الوراثي العائلي في المملكة
وصلة دائمة لهذا المحتوى : https://www.mnbr.news/48057.html
تناول المكسرات يخفض الوفاة مبكراً ويقي الجسم من أمراض القلب و السرطان
وصلة دائمة لهذا المحتوى : https://www.mnbr.news/43718.html
عقار جديد يحمي من النوبات القلبية ويحد من وفيات السرطان
وصلة دائمة لهذا المحتوى : https://www.mnbr.news/43041.html
ابتكار أنواعاً مختلفة من العلكة للكشف عن السرطان
وصلة دائمة لهذا المحتوى : https://www.mnbr.news/27858.html
دراسة تحذر من المطهرات الكيماوية
وصلة دائمة لهذا المحتوى : https://www.mnbr.news/26975.html
دراسة: بدانة الرجال تعرضهم للإصابة بسرطان الكبد
وصلة دائمة لهذا المحتوى : https://www.mnbr.news/26015.html